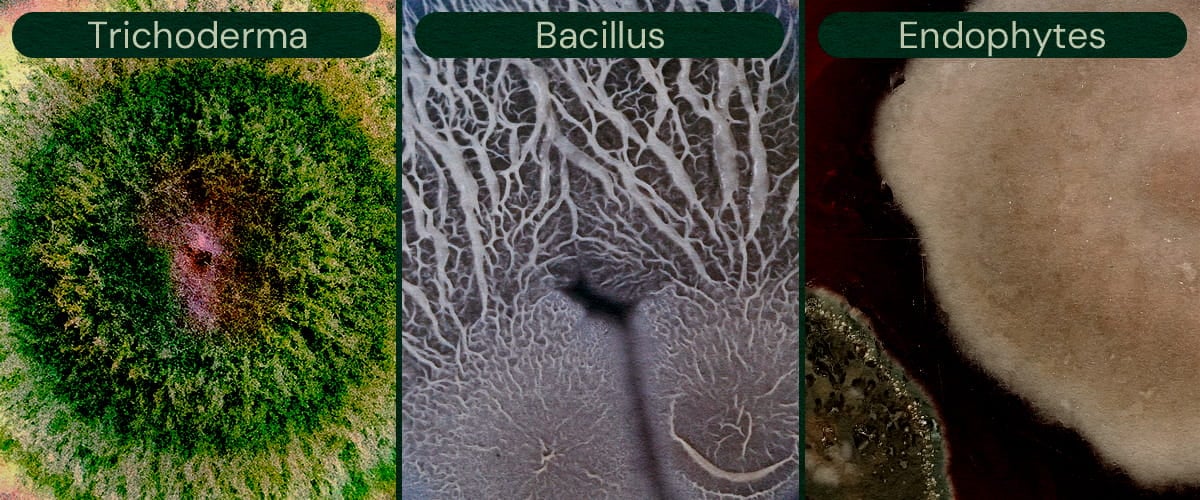
Image showcasing Trichoderma, Bacillus, and Endophytes as microbial biocontrol agents for cannabis, aiding in pest control and disease prevention.

.

Microbial Biocontrol: The Solution to Fungal Pathogens in Cannabis?
Fungal pathogens like Botrytis, Fusarium, and powdery mildew threaten cannabis crops, but beneficial microbes offer natural protection. Learn how Trichoderma, Bacillus, and endophytes combat fungal infections and discover how soil amendments, foliar sprays, and integrated pest management can help you grow healthy cannabis, all without chemicals.
Contents:
Microbial biocontrols such as Trichoderma and Bacillus can suppress common cannabis pathogens, including powdery mildew, Botrytis, and Fusarium. They are most effective when matched to the target, applied early, and delivered consistently through soil drenches and foliar sprays. The best results are achieved when these inputs are paired with a holistic integrated pest management (IPM) plan that utilises environmental control, sanitation, and consistent reapplication.
Whether you grow indoors or outdoors, cannabis plants are susceptible to a host of health issues, from nutrient deficiencies and pest infestations to microbial infections. Amongst all these threats, fungal pathogens are some of the most serious, potentially contaminating entire harvests and wiping out plants altogether.
Given their potentially devastating effects, many growers opt to use harsh chemicals to protect their plants from pathogens like powdery mildew, Botrytis, and Fusarium. However, some cultivators are also turning to organic and eco-friendly methods to maintain the health and productivity of their crops. When used correctly, organic pest control for cannabis helps keep these dreaded fungal diseases at bay.
Below, we’ll explore microbial biocontrols and how they can help to manage fungal pathogens in cannabis. Get to know your top microbial allies below!
Key Takeaways
- Fungal pathogens like Botrytis, Fusarium, and powdery mildew are major threats to cannabis and can destroy entire harvests.
- Beneficial microbes, including Trichoderma, Bacillus, and endophytes, can prevent and combat these fungal infections naturally.
- Microbial biocontrols are most effective when tailored to specific pathogens and applied strategically via soil amendments or foliar sprays.
- Integrated pest management combines microbes, environmental controls, and sanitation to ensure sustainable, chemical-free cannabis cultivation.
What Are Microbial Biocontrol Agents?
Biological pest control for cannabis doesn’t only involve the cultivation of companion plant species and the deployment of beneficial predatory insects. This holistic strategy also includes administering different strains of fungi and bacteria that help to prevent and combat common cannabis diseases on the cellular level.
Advances in microbiology have shown that all organisms rely on healthy and diverse communities of microbes to assimilate nutrients and fight off diseases. This applies to the gut and skin of humans as it does to the foliage, roots, and internal tissue of plants, including cannabis.
Through the application of beneficial microbes, growers can both prevent fungal infections and fight them when they occur. Some key microbial allies in the cannabis garden and grow room include:
- Trichoderma: Present in all soils, fungi of the Trichoderma genus form mutualistic relationships with many plants, entering their tissues and helping to fight off common root pathogens.
- Bacillus species: Bacillus is a species of beneficial rhizobacteria that helps to suppress pathogens and pests while boosting nutrient availability by decomposing organic matter.
- Endophytes: A range of different endophytes live within cannabis leaves, roots, and seeds. They’re known to produce antifungal and antibacterial compounds as well as improve a plant’s stress tolerance.

Common Fungal Pathogens in Cannabis
When learning how to prevent mould in cannabis, it certainly helps to get familiar with the beneficial microbes mentioned above. However, it’s just as important to know your enemy; a combined knowledge of both the good guys and bad guys will help you make informed and effective pest control decisions.
Of all the fungal pathogens that infect cannabis plants, Botrytis, Fusarium, and powdery mildew are amongst both the most common and the most serious.
Botrytis (Bud Rot)
Botrytis cinerea, often called bud rot, is a necrotrophic fungus that thrives in humid, poorly-ventilated conditions. It tends to strike cannabis plants during late flowering when dense buds create microenvironments with trapped moisture.
Botrytis’ life cycle begins with airborne conidia (asexual spores) that land on plant tissue and germinate when surface humidity is high. Hyphae then penetrate the leaves and release enzymes that kill the host’s cells. Ultimately, this infection manifests as a fuzzy, grey mould that coats cannabis flowers and has the potential to spoil entire harvests.
Fusarium
Fusarium species, particularly F. oxysporum and F. solani, are soil-borne fungi that cause wilt, root rot, and stem cankers in cannabis. Their life cycle starts with chlamydospores or macroconidia that form in soil or infected dead plant matter and germinate when they detect root exudates (organic compounds released into the soil from live roots).
Fusarium hyphae enter roots through wounds or natural openings and then colonise vascular tissues. Once inside a plant’s xylem, Fusarium produces microconidia that move upward with the plant’s flow of water, spreading the infection systemically. The symptoms of Fusarium-caused disease include vascular browning, chlorosis (yellowing foliage), wilting, stunted growth, and even plant death.
Powdery Mildew
Powdery mildew in cannabis is most often caused by Golovinomyces cichoracearum or related species; obligate biotrophic fungi that penetrate cannabis leaves and buds, feeding on the nutrients they contain.
To reproduce, powdery mildew covers its hosts in fine, white spores that have a powdery appearance. In severe cases, this layer of spores can block photosynthesis and contaminate mature flowers.
How Microbes Combat Fungal Pathogens
Agriculture is facing a crisis. Ever since the Green Revolution, the over-application of chemical fertilisers and synthetic pesticides, herbicides, and fungicides has caused great damage to soils across the world and the microbial communities that are key to their fertility.
Because of this, researchers are exploring both new and old ways to grow plants, including cannabis, organically. Advances in this area have discovered the crucial role of microbes that live not only in the soil, but in and on plants, too.
The authors of a 2025 paper[1] published in BMC Plant Biology found that “the phyllosphere, which includes the surfaces of plant leaves and stems, is one of the largest and most diverse microbial habitats on Earth, yet it remains understudied in plant-microbe interactions.”
This complex and yet untapped community of life likely plays a critical role in plant diseases. Instead of simply spraying the entire community with noxious chemicals, the use of microbial biocontrols works more naturally and selectively.
These microbes not only directly fight disease themselves, but also help plants become stronger in the face of pathogens. For example, Trichoderma produces antimicrobial compounds, but also makes plants more capable of repelling diseases by reducing stress, boosting nutrient uptake, and increasing photosynthesis.
Choosing the Right Microbial Products
In order to tweak the phyllo- or rhizosphere (root zone) properly, you need to consider both the pathogen you’re fighting and the properties of the cannabis biocontrol you’re thinking of applying. The most common biocontrol products for cannabis mould defence include:
- Trichoderma: Excels in suppressing root pathogens like Fusarium and Pythium. Supports overall plant health in terms of growth, yield, and stress reduction.
- Bacillus subtilis: Produces lipopeptides that disrupt fungal cell membranes and compete for space and nutrients. Primarily targets powdery mildew and Botrytis.
- Lactic acid bacteria: Produce lactic acid, lowering pH on plant surfaces to inhibit pathogen germination. Effective against powdery mildew. However, Oidioprot serves as a more well-rounded and more effective solution.
- Chaetomium species: Produce potent antifungal metabolites such as chaetoglobosins and cellulases that degrade pathogen cell walls. They work well against Botrytis, powdery mildew, and Fusarium.
Application Methods and Best Practices
So, how exactly should you go about using Trichoderma to control Botrytis bud rot in cannabis? Or how should you deploy lactic acid bacteria against powdery mildew? Check out the following application methods for the best results.
Soil Amendment
Incorporating microbial biocontrols directly into the soil creates a protective barrier around the root system, the primary entry point for many fungal pathogens. Trichoderma and certain Bacillus species can establish themselves in the rhizosphere, competing with and directly antagonising soil-borne threats like Fusarium. In terms of prevention, the goal is to achieve early colonisation ahead of pathogens. Mix powders into your initial growing medium, apply liquid drenches early in the vegetative phase, and reapply regularly throughout the growing cycle.
Foliar Sprays
Foliar application is particularly effective against pathogens that colonise leaf surfaces, as it administers beneficial microbes exactly where they’re needed. Bacillus subtilis sprays form a living shield on plant surfaces, releasing antifungal compounds and occupying infection sites. Likewise, lactic acid bacteria are effective when applied to infected leaves, where they immediately begin producing lactic acid.
For the best results, foliar sprays should be applied during early mornings or evenings to minimise UV degradation and ensure prolonged leaf surface moisture. They’re best deployed against powdery mildew, Botrytis, and other pathogens that colonise aerial plant parts.
Hydroponic Compatibility
Hydroponic growing operations present unique challenges for microbial biocontrol due to constant or near-constant nutrient flow, sterilisation protocols, and low organic matter levels. Not all beneficial microbes thrive in these environments, but certain strains of Bacillus and Trichoderma are formulated for hydroponic use and can colonise root surfaces even when they’re suspended in nutrient solutions. Likewise, foliar sprays are also effective in hydroponic setups.
Preventative Care & Integrated Management
Effective fungal disease prevention in cannabis comes from more than simply applying microbial products; it requires a fully integrated pest management (IPM) plan where beneficial organisms work alongside cultural, environmental, and sanitation measures. This combined approach includes:
- Environmental optimisation: Keeping relative humidity within the right range helps reduce the germination of Botrytis, powdery mildew, and Fusarium spores. Constant air circulation also prevents stagnant “hot pockets” in dense canopies.
- Sanitation and crop hygiene: Cleanliness is a cornerstone of any IPM strategy. Disinfect tools between use in different grow rooms or areas of the garden, and regularly clean your grow tents between cycles. In hydro systems, frequently sanitise your reservoirs.
- Nutrient and soil health management: Balanced nutrition supports stronger immune responses, making cannabis less susceptible to infections. In living soil setups, maintaining organic matter and microbial diversity ensures long-term suppression of harmful organisms through competitive exclusion.
Microbial Biocontrol in Practice
Successful cannabis cultivation demands both knowledge and adaptability, especially in the face of fungal infections. By understanding pathogens, harnessing beneficial microbes, and integrating cultural and environmental controls, growers can support the health of their plants and maximise their yields without over-reliance on chemicals.
Evidence-based strategies, refined through personal experience, create resilient, sustainable growth systems capable of thriving even under unique challenges and scenarios. Incorporating microbes into your grow won’t just help to protect your plants against infections; it promises to enhance their soil fertility, support their overall health, and even increase the size and quality of their yields.
